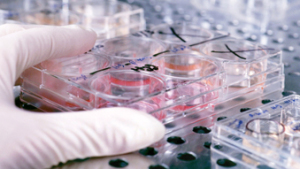
Residue Studies And GLP In Brazil

Celso Zaccaria
Zaccaria is a biologist and quality assurance manager, BIOAGRI Laboratorios Ltda.
Latest News
Biopesticides
Micropep Files First Regulatory Submissions for Novel Peptide Biofungicide with a New Mode of Action
Brazil and Paraguay submissions kick off a global registration...
AgriBusiness Global Report
Neil DeStefano on How Biologicals Companies Can Achieve Success in the U.S.
In this AgriBusiness Global Report, Neil DeStefano, Principal of...
ABG Update Feature
Beyond Tariffs: The Bigger Trends Emerging from SACA 2026
Nearly 2,000 attendees gathered to discuss market outlooks, sourcing...
Industry News
Seed Industry Applauds EU Approval of New Genomic Techniques Regulation
The legislation establishes a modern, science-based regulatory framework for...